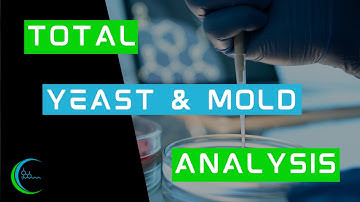
Should labs test for Total Yeast and Mold Analysis in cannabis flower?

⬇ DOWNLOAD NOW
Kalau muncul iklan pop-up, tutup lalu klik tombol kembali
Download lagu Putting Total Yeast and Mold to the Test with Jini Curry secara gratis hanya untuk keperluan promosi. Dukung artis favorit kamu dengan membeli musik original di iTunes atau platform resmi lainnya.
 Total Yeast and Mold - A Comparison Study - Jini Glaros, M.S.
Total Yeast and Mold - A Comparison Study - Jini Glaros, M.S.
 Total Yeast and Mold Testing in Cannabis: A Comparison of Different Techniques
Total Yeast and Mold Testing in Cannabis: A Comparison of Different Techniques
 Total Yeast and Mold - Turnaround Time
Total Yeast and Mold - Turnaround Time
 Total Yeast & Mold Count (Total Fungal Count)_A Complete Procedure (BAM, Ch-18)
Total Yeast & Mold Count (Total Fungal Count)_A Complete Procedure (BAM, Ch-18)
 Managing Total Yeast and Mold with Zamir Punja, PhD
Managing Total Yeast and Mold with Zamir Punja, PhD
 Fast and Simple YEAST & MOLD testing | mybiolumix.com
Fast and Simple YEAST & MOLD testing | mybiolumix.com
Should labs test for Total Yeast and Mold Analysis in cannabis flower?
Should labs test for Total Yeast and Mold Analysis in cannabis flower?
 How To Make YPD Plates
How To Make YPD Plates